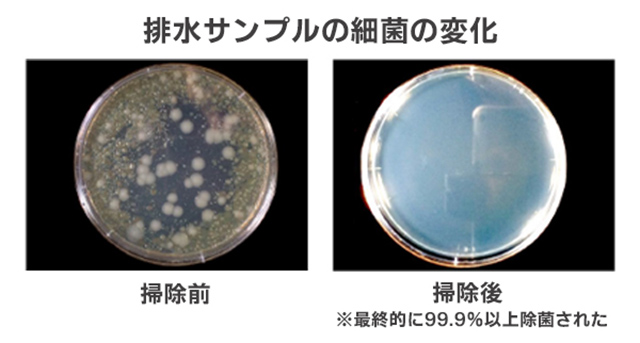

水まわりのお掃除
ドラム式洗濯機が臭い!?汚れやカビを落とす掃除方法とプロの洗濯機クリーニング
ドラム式洗濯機本体や洗濯物から嫌なニオイがしたことはありませんか?
乾燥機能が付いたモデルも多く、人気の高いドラム式洗濯機ですが、「洗い上がった服がカビ臭い」「洗濯機から悪臭がする」と悩む人は少なくありません。たくさんの人を悩ませるこのニオイは、カビや雑菌、溶け残った洗剤など、さまざまなものが原因で発生します。
この記事では、ドラム式洗濯機から臭いニオイが発生してしまう理由や、ニオイを解消するための掃除方法、ニオイの予防方法を紹介します。
さらに、プロに洗濯機クリーニングを依頼するメリットについても詳しく解説していますので、ドラム式洗濯機のニオイにお悩みの方は、ぜひ参考にしてください。

目 次
ドラム式洗濯機と縦型洗濯機の違い
ドラム式洗濯機と縦型洗濯機は、構造や洗い方が大きく異なります。
まずは、それぞれの特徴を理解して、ドラム式洗濯機の汚れやすい部分を把握しておきましょう。
ドラム式洗濯機と縦型洗濯機の特徴

| 特徴 | |
|---|---|
| ドラム式洗濯機 | 縦型洗濯機 |
| ・衣類を持ち上げて落とすたたき洗い ・ドラムの角度を利用して少ない水量で洗う ・洗濯物がほぐされて空気に触れやすく乾燥が早い |
・パルセーターで起こした水流によるもみ洗い ・たっぷりの水量で洗う ・乾燥に時間がかかる |
ドラム式洗濯機と縦型洗濯機の汚れ方・メンテナンスの違い
ドラム式洗濯機と縦型洗濯機は構造が違うので、汚れる場所やメンテナンスする場所にも違いがあります。
水の使用量が少ないドラム式洗濯機は汚れにくいと思われるかもしれませんが、実は縦型には無いパーツも多く、外側からは見えない場所にホコリやカビなどの汚れがたまりやすい構造になっています。

| 汚れやすくメンテナンスが必要な場所 | |
|---|---|
| ドラム式洗濯機 | 縦型洗濯機 |
| 洗濯槽 洗剤投入ケース 排水(糸くず)フィルター 乾燥フィルター ドアのゴムパッキン 洗濯パン 排水口 |
洗濯槽 洗剤投入ケース 糸くずフィルター 洗濯パン 排水口 |
これらのパーツは、使い続けるうちにホコリや石鹸カス、洗濯物から出た繊維クズや皮脂汚れ、食べカスなどが付着していき、カビも発生しやすい場所です。
汚れを放置すると洗濯物が臭くなるだけでなく、洗濯物が乾きにくくなったり排水トラブルを引き起こしたりする恐れがあるため、定期的にメンテナンスを行いましょう。
ドラム式洗濯機で臭いニオイが発生する主な原因
ドラム式洗濯機を使っていると、洗濯が終わったあとにドアを開けた瞬間、もわっとした嫌なニオイがすることがあります。
このようなニオイの多くは、洗濯槽の裏側や排水部分など、見えにくい場所にたまった汚れやカビが原因です。
ここでは、ドラム式洗濯機から臭いニオイが発生する主な原因について解説します。
洗濯槽のカビや雑菌の繁殖
水を使う洗濯機の内部は、湿度が高い状態になりがちです。特に洗濯槽の裏側は湿気がこもりやすく、カビや雑菌が繁殖しやすい環境です。
洗濯物から出る汚れを栄養にしてカビや雑菌が繁殖すると、嫌なニオイの原因になります。この状態を放置すると、せっかく洗った洗濯物にニオイが移ってしまうこともあります。
排水フィルターや乾燥フィルターにたまったゴミ
排水フィルターや乾燥フィルターにたまったホコリや糸くずなどのゴミが湿気と混ざると、雑菌が繁殖します。
特に排水フィルターは洗濯水が通る場所なので、雑菌によるヌメリや黒ずみが発生しやすく、ニオイの原因となることがあります。
排水口・排水ホース・洗濯パンの汚れ

排水口や排水ホースは、洗濯で出た汚れた水が流れ込む部分です。ここに汚れがたまると、下水のような悪臭が発生することがあります。
また、洗濯機の下にある洗濯パンや床にも注意が必要です。一見キレイに見えても、専用の道具で洗濯機を持ち上げてみると、思った以上に汚れていることが少なくありません。洗濯機と洗濯パンの間に入り込んだホコリやこぼれた洗剤、排水ホースや排水口からあふれた排水、湿気などが混ざり合い、汚れとしてこびりついてしまうのです。

そのまま放置すると、カビや雑菌が発生してヌメリや悪臭を引き起こすだけでなく、排水口が詰まってしまうリスクもあります。
洗剤・柔軟剤の使いすぎによる残留物
洗濯の際に洗剤や柔軟剤を入れすぎると、溶け切らなかった洗剤が洗濯機の内部に残り、カビや雑菌のエサになってしまいます。
洗剤や柔軟剤は適量を守り、洗濯物の詰め込みすぎにも気をつけましょう。
臭いニオイの対策!ドラム式洗濯機の掃除方法と掃除頻度
ドラム式洗濯機の臭いニオイを防ぐには、定期的なお手入れが欠かせません。
簡単にできる掃除方法を紹介しますので、実践してみましょう。必ずご自宅の洗濯機の取扱説明書を確認してから、掃除を行ってください。
ゴムパッキンの掃除
ドラム式洗濯機のドアの内側には、水が漏れないようにゴムパッキンが付いています。この部分が汚れたままだとカビが繁殖してしまうので、キレイにしておきたい箇所です。
ゴムパッキンの掃除方法
①ゴムパッキンの内側にたまった汚れを、やわらかい布やウエットティッシュなどで優しく水拭きします。

②汚れがひどい場合は、ゴムパッキンの内側にアルカリ電解水をスプレーし、10分程度浸け置きして、やわらかい布で拭きます。ホコリや石鹸カスなどの汚れが残らないよう、しっかり拭き取りましょう。

③水分が残らないように、乾拭きして仕上げます。
ゴムパッキンの掃除頻度
ゴムパッキンは、洗濯のたびに軽く拭いておくことをオススメします。
水分や汚れが残ったままの状態で放置するとカビが繁殖し、洗濯時にそのカビが衣類へ移ってしまうことがあります。洗濯後はゴムパッキンを乾拭きして、水分や汚れを残さないようにしましょう。
排水フィルター(糸くずフィルター・ゴミ取りフィルター)の掃除
ドラム式洗濯機のメンテナンスで忘れてはいけないのが、排水フィルター(糸くずフィルター・ゴミ取りフィルター)です。
排水フィルターは洗濯機を正面から見て、右下か左下に設置されています。
排水フィルターの掃除は、ドラム内に水が残っていないことを確認してから行いましょう。ドラムの中に水が入っているときに排水フィルターを取り外すと、水が溢れ出てしまいます。
排水フィルターの掃除方法
①排水フィルターを取り外します。排水フィルターに残った水が出てくる場合があるので、雑巾を添えながら外すとよいでしょう。

②フィルターにたまった糸くずや、付着した汚れを取り除きます。細かな隙間はブラシで掃除しましょう。
汚れがひどい場合は、ゴミを取り除いた後にアルカリ電解水をスプレーして、しばらく浸け置きしてからブラシで磨きます。

③排水フィルターを元に戻します。しっかり取り付けられていないと、水漏れの原因になることがあります。機種によってはエラーが表示されることもあるため、確実に取り付けましょう。
排水フィルターの掃除頻度
週1回を目安に、排水フィルターの糸くずや髪の毛などのゴミを取り除き、水で洗い流しましょう。
乾燥フィルターの掃除

乾燥機能付きのドラム式洗濯機には、洗濯機上部に乾燥フィルターが設置されています。
フィルターが詰まると、乾燥時間が長くなったり、乾燥ムラが起きたりすることがあるので、フィルターに付いた糸くずやホコリを取り除く必要があります。
乾燥フィルターの掃除方法
①乾燥フィルターを取り外します。乾燥内部フィルターがある場合は、二つのフィルターを取り外してください。
②フィルターにたまった糸くずやホコリを捨てます。フィルターの目に付着した細かいゴミはブラシを使って取り除きましょう。
③汚れがひどい場合は水洗いします。シャワーを当てながら、細かいブラシでフィルターについたホコリや汚れを優しく掻き出して、洗い流します。
④水洗いした後は、乾燥フィルターをしっかり乾かしてから元に戻します。
乾燥フィルターの掃除頻度
乾燥運転のたびにフィルターにたまったゴミを取り除いてください。
一部の高性能な機種では、自動で乾燥フィルターを掃除してくれる機能が備わっています。その場合は、取扱説明書に従って指定の頻度で掃除してください。
洗濯槽の掃除

洗濯槽の裏側には、カビや石鹸カスなどの汚れがこびり付いてしまいます。汚れを落とすには、洗濯槽クリーナー(ドラム式洗濯機用)を使います。
機種によっては塩素系の洗剤が使用できない場合があるため、取扱説明書を確認してから層洗浄を行ってください。
洗濯槽の掃除方法
①洗濯機のドアを開け、洗濯槽に洗濯槽クリーナーを入れます。
②ドアを開けてもこぼれないくらいまでお湯を入れます。
お湯は熱湯ではなく、40~50℃程度の温度にしてください。ほとんどのメーカーで、50℃以上のお湯は使用不可とされています。
③槽洗浄コースで洗濯する。
多くのドラム式洗濯機には「槽洗浄コース」が設定されているので、取扱説明書で確認しましょう。槽洗浄コースがない場合は、標準コースにしてください。
洗濯槽の掃除頻度
月1回を目安に、洗濯槽の洗浄を行うことをオススメします。
排水口・洗濯パンの掃除
排水口は洗濯物から出た汚れや洗剤、ヌメリなどでドロドロに汚れていることも少なくありません。排水口の汚れは臭いニオイの原因になりやすいので、キレイにしておきたい箇所です。
また、洗濯パンはホコリがたまりやすい箇所です。洗濯パンのホコリが排水口に流れ込むこともあるため、こちらも掃除しておきましょう。
排水口・洗濯パンの掃除方法
①隙間掃除用のワイパーなどを使って、床または洗濯パンを水拭きします。
②排水口から排水ホースを外します。

③排水口の目皿(網状のフタ)や排水トラップ(筒状の部品)などの部品を取り外し、浴室用洗剤とブラシを使って洗います。

④排水口の縁や中についたゴミを取り除き、ブラシで磨きます。

⑤外した部品を元に戻して、排水ホースをしっかりと取り付けます。
洗濯機がかさ上げされていないと、排水口が洗濯機の下に隠れていたり、洗濯パンとの隙間が狭くて掃除しにくかったりします。自分で掃除するのが難しいようなら、業者に依頼しましょう。
排水口・洗濯パンの掃除頻度
月に1回程度を目安に掃除するとよいでしょう。
合わせて読もう:洗濯機の下を掃除したい!簡単なお手入れや掃除方法を紹介
臭いニオイを防ぐための予防法

ドラム式洗濯機は、構造上の理由から、内部に湿気や汚れがたまりやすくなっています。
臭いニオイを防ぐには、日ごろのちょっとしたお手入れや習慣が大切です。
ここでは、簡単に実践できるニオイの予防法を紹介します。
定期的に掃除する
乾燥フィルターは乾燥運転を使うたびに、排水フィルターは週に1回を目安に掃除しましょう。
ホコリや糸くずを放置すると、カビの繁殖やニオイの発生につながります。
ドア部分のゴムパッキンもカビが繁殖しやすい場所です。洗濯したあとはこまめに水気や汚れを拭き取り、黒ずみが見え始めたら早めに対応しましょう。
また、月に1回は洗濯槽を洗浄することで、カビや雑菌を早めにリセットできます。
洗濯する前に目につく汚れは取り除く
洗濯物に付着した泥汚れは、洗濯機に入れる前にシャワーなどでさっと洗い流しておきます。糸くずやペットの毛などもあらかじめ取り除いてから洗濯すると、洗濯機に汚れがたまりにくくなります。
洗剤・柔軟剤は適量を守る
洗剤や柔軟剤を入れすぎると、溶け切らなかった洗剤が洗濯機内部に付着し、それを栄養源にしてカビや雑菌が繁殖しやすくなります。
液体洗剤はキャップ、粉末洗剤は計量スプーンで正確に量り、適量を使いましょう。
すすぎ1回に対応している洗剤を使う場合でも、「すすぎ2回」に設定することで洗剤の溶け残りを防ぎやすくなります。
洗濯後はドアを開けて内部を乾燥させる
洗濯後すぐにドアを閉めてしまうと、湿気がこもってカビが繁殖しやすい状態になります。
洗濯後はドアを少し開け、内部に風を通して乾燥させましょう。脱衣所など狭い空間に洗濯機を設置している場合は、換気扇を回したり窓を開けたりして湿気を逃がすことも大切です。
さらに、ゴムパッキンや洗濯槽に残った水分をタオルで軽く拭き取ることで、乾燥が早まります。
また、洗濯物をドラムの中に入れっぱなしにするのも避けましょう。洗濯物は洗濯する直前までドラムに入れない・洗濯が終わったらすぐに取り出すように心がけるのも、カビやニオイの予防になります。
防カビ消臭グッズを使う
洗濯機の中に洗濯物と一緒に入れて洗うだけで、カビやニオイを抑えるグッズも販売されています。日常のお手入れに加えて、こうしたグッズを活用するのも臭いニオイを予防するのに効果的です。
掃除してもニオイが取れないときは業者に洗濯機クリーニングを依頼する

ドラム式洗濯機は構造が複雑で、家庭での掃除では手が届かない部分が多くあります。特に洗濯槽の裏側や乾燥ダクトの奥にはカビやホコリが蓄積しやすく、見えないところに汚れがこびりついている可能性が高いです。
自分で掃除しても臭いニオイが解消しないときは、専門の業者に洗濯機クリーニングを依頼しましょう。
業者に依頼するメリット
ドラム式洗濯機を分解して掃除しようとすると、故障や水漏れにつながる恐れがあります。
洗濯機内部の掃除は、専門の技術を持ち、ドラム式洗濯機の構造を正しく理解しているプロに依頼したほうが安全です。
ここでは、ドラム式洗濯機のクリーニングを業者に依頼する主なメリットを紹介します。
メリット1:洗濯槽の裏側など手の届かない内部まで洗浄できる
家庭での掃除で落とせるのは、表面に付着したカビやホコリだけです。
しかし実際には、洗濯槽の裏側や排水ホースの奥など、手が届かない部分にこびりついたカビや雑菌が臭いニオイの原因であることがほとんどです。
業者によるクリーニングなら、このような見えない場所まで徹底的に洗浄し、洗濯機の内部に蓄積した汚れを取り除けます。
メリット2:分解してホコリやカビを根本から除去
乾燥機能を使うことの多い家庭では、乾燥フィルターの奥やダクト内に大量のホコリがたまっていることが少なくありません。このホコリが湿気と混ざると、臭いニオイが発生する原因になります。
業者なら専用の機材を使い、洗濯機内部のホコリやカビを根本から取り除きます。
メリット3:洗濯機の劣化やトラブルの予防
内部に汚れがたまったまま洗濯機を使い続けると、モーターに負担がかかって故障したり、排水トラブルが起きたりする場合があります。
業者による定期的な洗濯機クリーニングは、部品の劣化やトラブルを未然に防ぎ、洗濯機を長く快適に使うためのメンテナンスとしても有効です。
おそうじ本舗の「ドラム式洗濯機クリーニング(※1)」
日常的なお手入れをしていても、ドラム式洗濯機の中はカビや雑菌がビッシリということもあります。
洗濯物のニオイが気になる、1年以上洗濯機クリーニングをしていない、掃除する時間が無いという場合は、おそうじ本舗の洗濯機クリーニング(※1)を検討してみてください。
(※1)汚れの状況により、完全に除去できない場合がございます。
99.9%以上の除菌力を誇るドラム式洗濯機クリーニング(※2)
H3:99.9%以上の除菌力を誇るドラム式洗濯機クリーニング(※2)
掃除が難しく、汚れがたまりやすい箇所は洗濯槽の裏側です。
通常は見えない箇所なので、掃除してもキレイになったのか分かりにくいですが、おそうじ本舗では、洗濯機クリーニングの前後にルミテスターという検査キットを使用して洗濯槽の汚れを数値で測定するので、洗浄効果が一目で分かります。

生物由来の汚れや菌などの一部成分を発光させた数値を測定

おそうじ本舗のドラム式洗濯機クリーニングでは、除菌率99.9%(※2)の除菌洗浄剤を採用しています。
これらは研究機関との共同開発によって生まれたオリジナル商品で、洗濯槽の裏側に付着した菌や汚れを徹底的に除去する高い洗浄力と、部品を傷つけない上質な仕上がりを実現しています。
(※2)当社調べ。微生物培養試験(一般細菌群)にて効果を確認。完全分解洗浄オプションを付けた場合は洗濯機を分解しパーツごとに洗浄します。全ての菌を除去するものではありません。
一般的に使用されている洗浄剤は掃除後に塩素のニオイが強く残るため、洗浄作業と塩素のニオイが消えるまで、合計で12時間以上かかることもあります。もちろん、その間は洗濯機が使えません。
一方で、おそうじ本舗オリジナル洗浄剤は、塩素臭が残らないため、洗濯機クリーニング後すぐに洗濯機が使えます。
乾燥フィルターのクリーニング
ドラム式洗濯機で便利な機能のひとつが乾燥機能です。
しかし、乾燥に時間がかかるようになったり、仕上がりが湿っぽく感じたりする場合は、乾燥フィルターを外してホコリを取るだけのメンテナンスでは不十分かもしれません。
メーカーによって乾燥機能の構造は異なりますが、長く使ううちに内部にホコリが蓄積してしまうのはどの機種でも同じです。こうした見えない部分のホコリは、通常の掃除ではなかなか取り除けません。
おそうじ本舗のドラム式洗濯機クリーニングでは、特殊な器具や長いブラシを使って、フィルターの奥に付着したホコリまでキレイに除去します。
【事例①】Iさん宅 日立製ドラム式洗濯機

奥からズルズルとホコリの塊が出てきました。

ホコリを集めると、これほどの量になることも!
見えない場所にもホコリがびっしり付着していることはめずらしくありません。
【事例②】Yさん宅 パナソニック製ドラム式洗濯機

ホコリがたまると乾燥の効率が下がり、洗濯機に負荷がかかる場合もあるので、定期的にメンテナンスしましょう。
洗濯パンのクリーニング

ドラム式洗濯機本体の重量は、約70~90kgもあります。洗濯パンを掃除するには洗濯機本体をかさ上げしないとできませんが、素人が1人で行うのは難しいです。
おそうじ本舗では、洗濯パンのクリーニングもオプションで選ぶことができます。洗濯パンのオプションには排水口のクリーニングも含まれているので、洗濯機まわり全体をキレイにできます。
まとめ|ドラム式洗濯機のニオイを防いで長く使い続けるコツ
ドラム式洗濯機から発生する臭いニオイは、内部にたまったカビや雑菌、汚れの蓄積によるものがほとんどです。
汚れを放置するとニオイが洗濯物に移るだけでなく、乾燥効率の低下などにもつながるため、日常的な予防策と定期的な掃除が欠かせません。
ニオイを防ぐポイントは、汚れてから掃除するのではなく、普段から汚れをためない習慣を続けることです。
洗濯後は水気を拭き取り、洗濯機の内部に湿気を残さないようにしましょう。
また、洗剤や柔軟剤は適量を守り、溶け残りを防ぐことも大切です。さらに、月に1回を目安に、洗濯槽クリーナーを使って洗濯槽の汚れをリセットすると効果的です。
それでも落としきれない頑固なカビや汚れは、専門業者の洗濯機クリーニングを利用して徹底的に除去しましょう。プロの手で内部までキレイにすることで、不快なニオイを根本から解消し、ドラム式洗濯機を長く快適に使い続けられます。
この記事の監修者
ハウスクリーニング商品開発尾崎 真
おそうじ本舗の商品・サービス開発責任者を務め、国家資格であるハウスクリーニング技能士。 住まいのお掃除のコツや、暮らしに関するテクニックなど、お家で役立つ情報について満足していただける内容の改修を行っています。
おそうじ本舗 自分でできるお掃除術 監修者について

